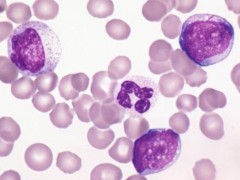

淋巴瘤 2017-12-18
淋巴瘤 2017-12-18

 淋巴瘤 2017-12-15
淋巴瘤 2017-12-15

 淋巴瘤 2017-12-14
淋巴瘤 2017-12-14
淋巴瘤 2017-12-14
淋巴瘤 2017-12-14

 淋巴瘤 2017-12-08
淋巴瘤 2017-12-08

 淋巴瘤 2017-12-08
淋巴瘤 2017-12-08

 淋巴瘤 2017-12-08
淋巴瘤 2017-12-08

 淋巴瘤 2017-12-08
淋巴瘤 2017-12-08

 淋巴瘤 2017-12-06
淋巴瘤 2017-12-06

 淋巴瘤 2017-12-06
淋巴瘤 2017-12-06

 淋巴瘤 2017-12-01
淋巴瘤 2017-12-01

 淋巴瘤 2017-11-27
淋巴瘤 2017-11-27

 淋巴瘤 2017-11-23
淋巴瘤 2017-11-23

 淋巴瘤 2017-11-23
淋巴瘤 2017-11-23

 淋巴瘤 2017-11-21
淋巴瘤 2017-11-21

 淋巴瘤 2017-11-20
淋巴瘤 2017-11-20

 淋巴瘤 2017-11-17
淋巴瘤 2017-11-17

 淋巴瘤 2017-11-08
淋巴瘤 2017-11-08

 淋巴瘤 2017-11-06
淋巴瘤 2017-11-06

 淋巴瘤 2017-11-03
淋巴瘤 2017-11-03



适合患者:NTRK1/2/3、ROS1或ALK基因重排突变的实体瘤
适合患者:只要存在NTRK融合,不限癌种
适合患者:晚期恶性实体瘤
适合患者:NTRK基因融合
适合患者:标准治疗失败或无标准治疗方案的晚期实体肿瘤患者
适合患者:晚期实体瘤患者
适合患者:晚期或转移性实体瘤
